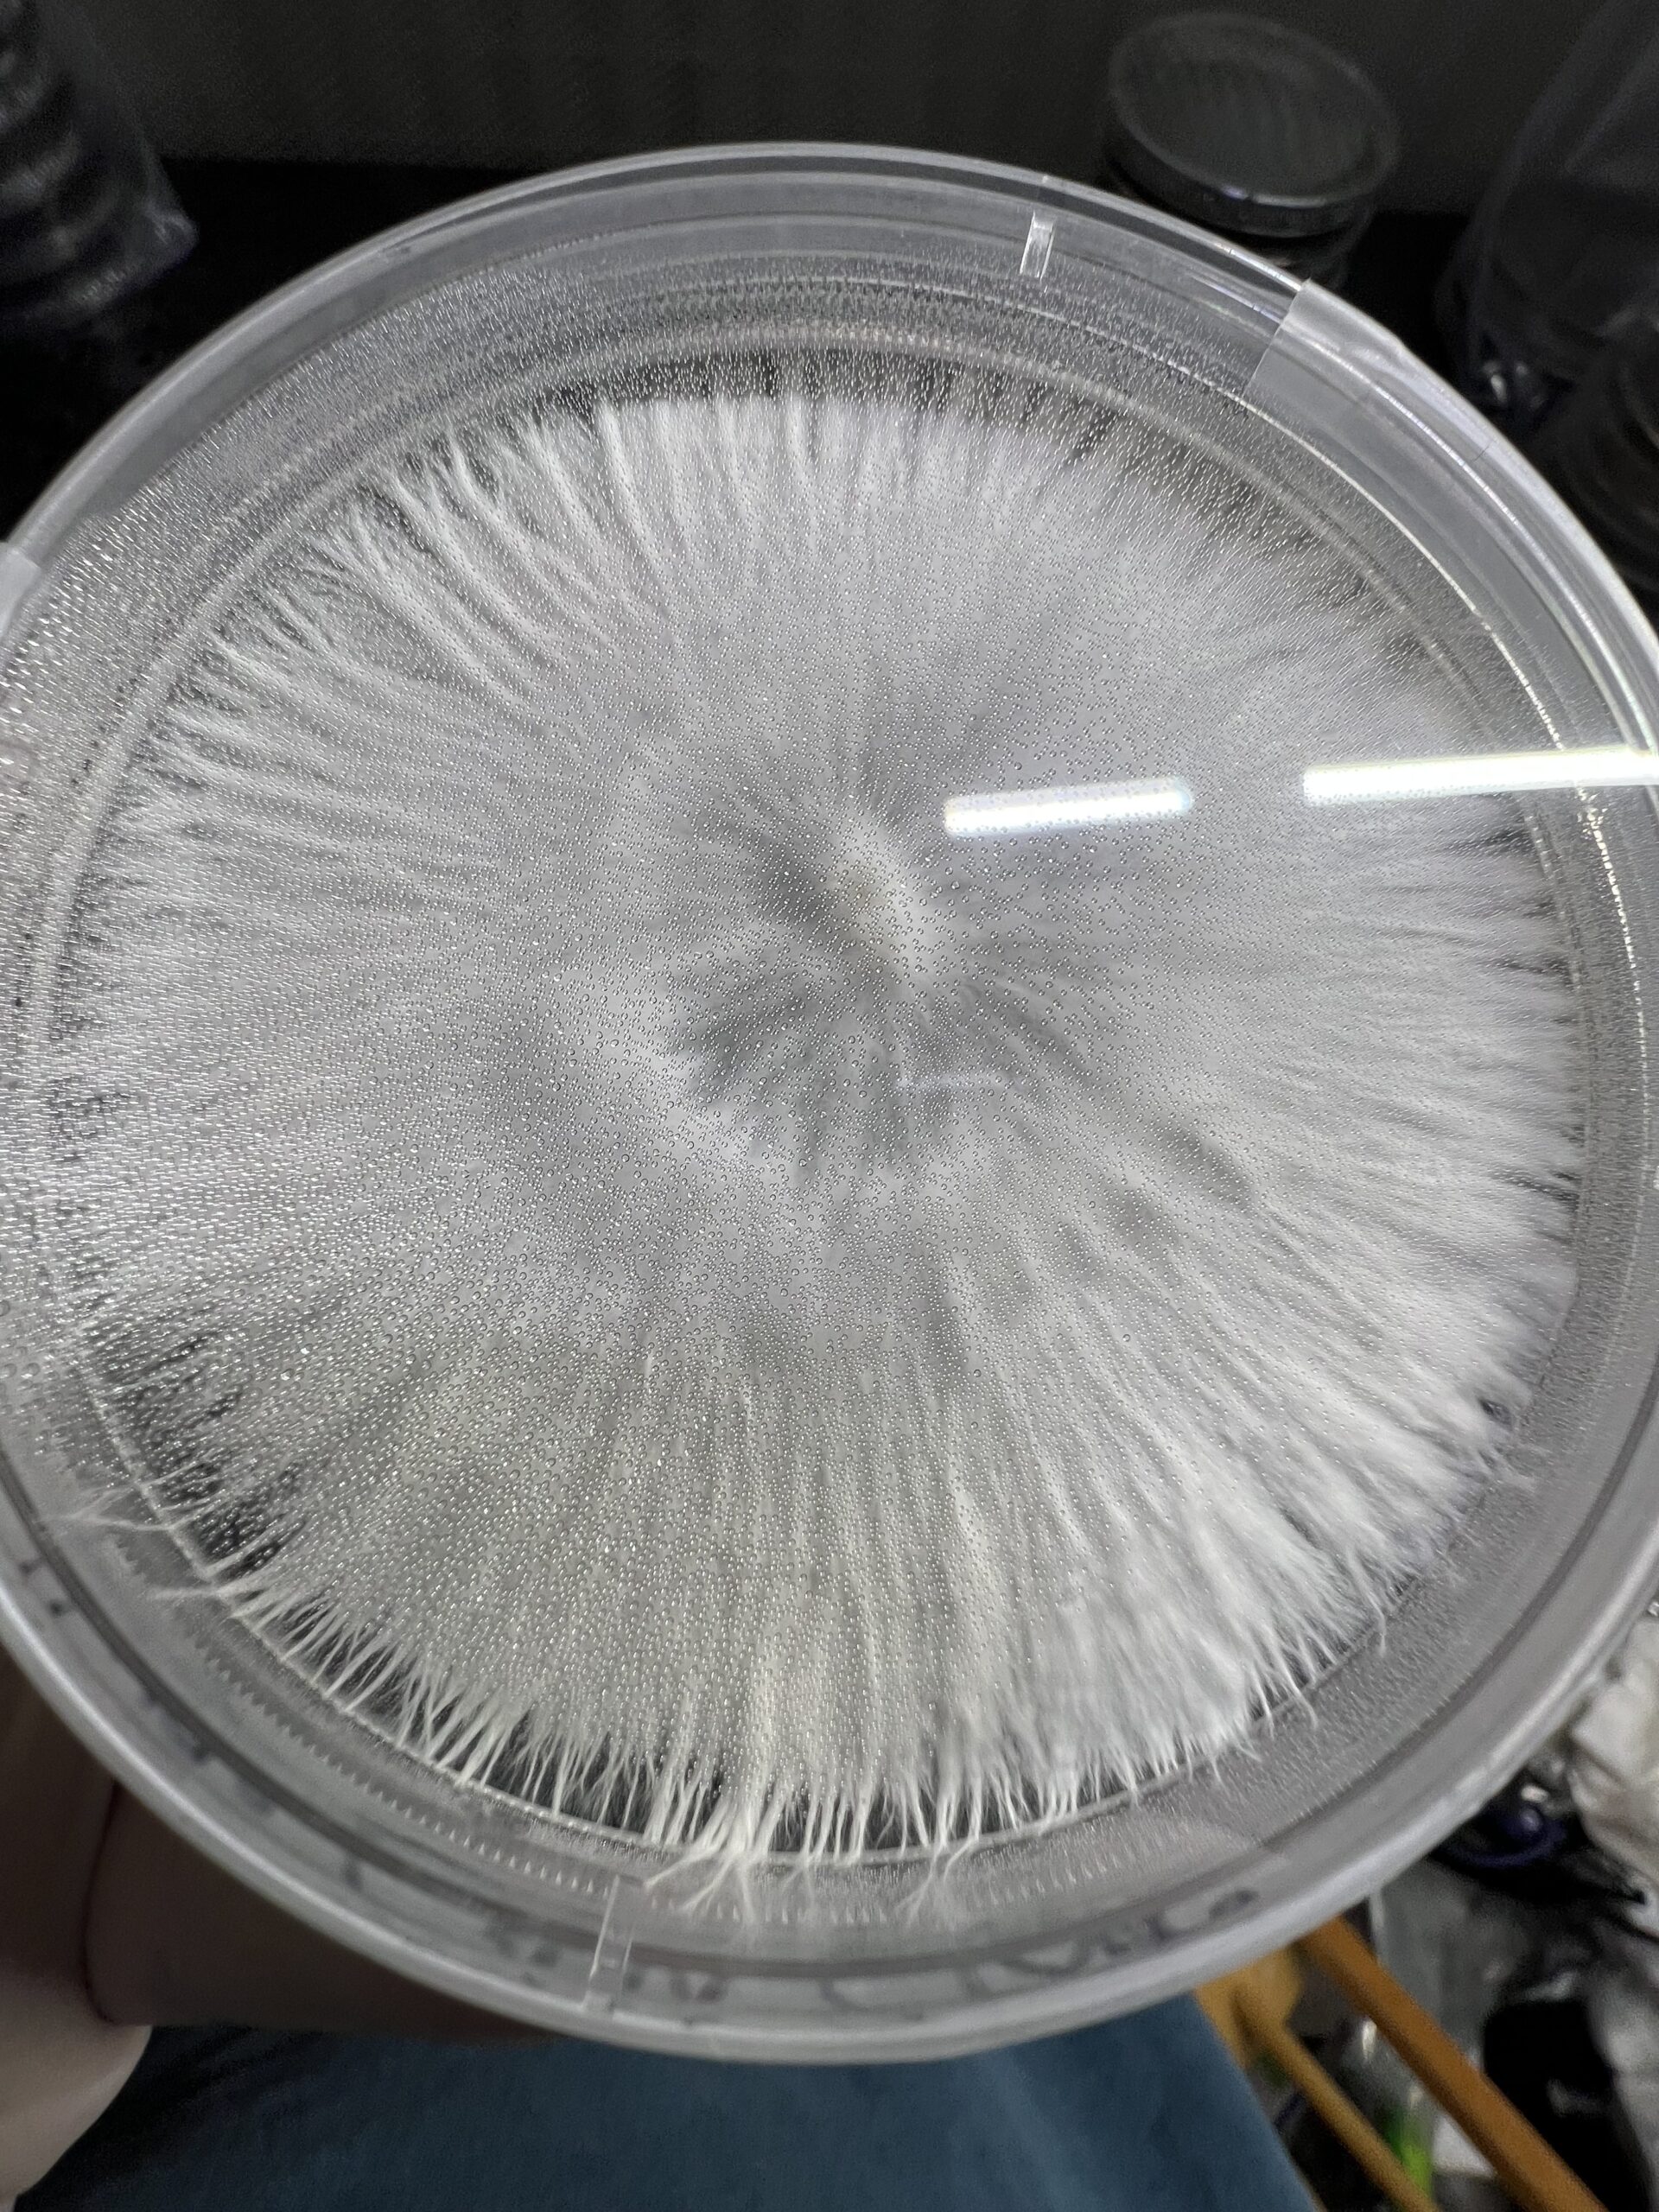

A little about the family at Rocky Mountain Family Mycology:
Hello, my name is Stephen Rey Martinez, I am the owner and operator of RMFM. My family and I are dedicated mushroom enthusiast. Our passion is mushrooms and mushroom growing and all the things in between. We are super passionate about what mushrooms have to offer the human body and our environment. Scientist are just now scraping the surface of the possibilities. My wife Amber, I and our three beautiful daughters and recent granddaughter are exited to share our pride and joy with you. We offer some of the best supplies, formulas, and cultures that have been in the works for many of years. We have been working on agar and liquid cultures recipes for many years. They have been fine tuned to promote and keep vigor, optimal production and growth of fungi. The products and genetics that we offer will speak for themselves. We are very exited to offer these to the public and all the citizen scientist out there. We stand behind all of the products we sell with a 100 percent satisfaction guaranteed. Soon we will be offering gourmet mushroom fruits to restaurants and the general public. We our pleased to share our love and passion with you or customers/friends. We wish you and your family the very best, and welcome to our family here at Rocky Mountain Family Mycology.
Welcome to the family at Rocky Mountain Family Mycology. Let us help you, if you can’t find what your looking for or need help choosing products please let us know, we are here to help. Please, feel free to send us a email with any questions, comments or concerns that you might have. We are more then happy to lend a helping hand with anything that we can.
RockyMountainFamilyMycology
Sale!
Actives, Cultures
Galactic Gorilla Research Plate
Original price was: $20.00.$16.00Current price is: $16.00.
Sv-13 x APE is Galactic Gorilla an amazing isolation. This one will take your research to the next level!
Units Sold: 8
Privacy Policy
Please refer to the privacy policy of sporeswaps.com
Terms and Conditions
Please refer to the terms and conditions of sporeswaps.com
Shipping costs
| Shipping from | United States (US) |
| Within United States (US) | $5.00 |
National Shipping Details
| Minimum shipping charge per order | $3.00 |
| Maximum shipping charge per order | $12.00 |
| Free shipping if the order spend is over | $50.00 |